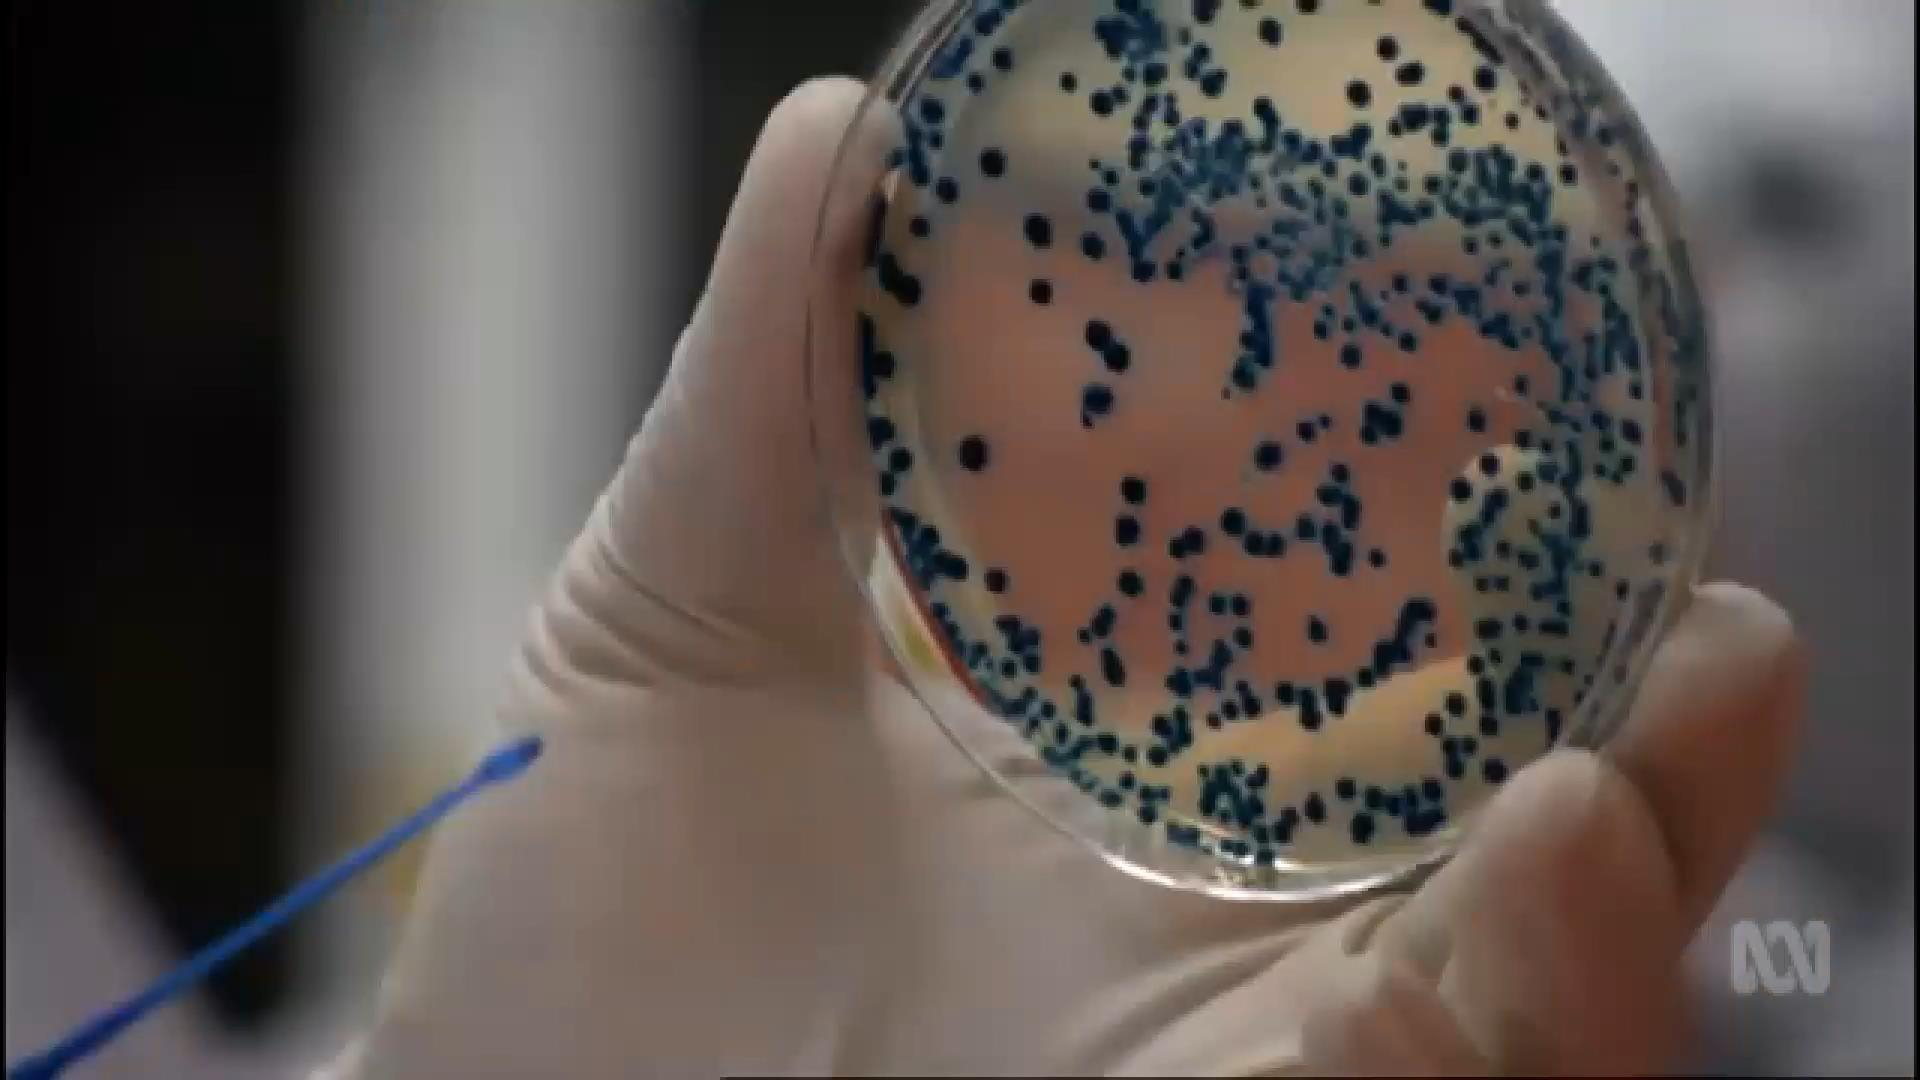
Зараженная сверхстойкой к антибиотикам бактерией женщина умерла в США

Жительница штата Невада долгое время была в Индии. Там сломала ногу и несколько раз была госпитализирована. В прошлом году летом вернулась на родину. Врачи обнаружили в его организме опасную бактерию – уже известную и изученную учеными. Однако ее новый штамм оказался сверхстойким ко всем антибиотикам.
После тщетных попыток, женщину спасти не удалось. Она умерла от септического шока.
Медики не исключают, что пациентка могла заразиться в одной из индийских больниц, где не соблюдаются санитарные нормы.
Читайте также: Стоимость некоторых лекарств в Украине завышена в более чем 10 раз